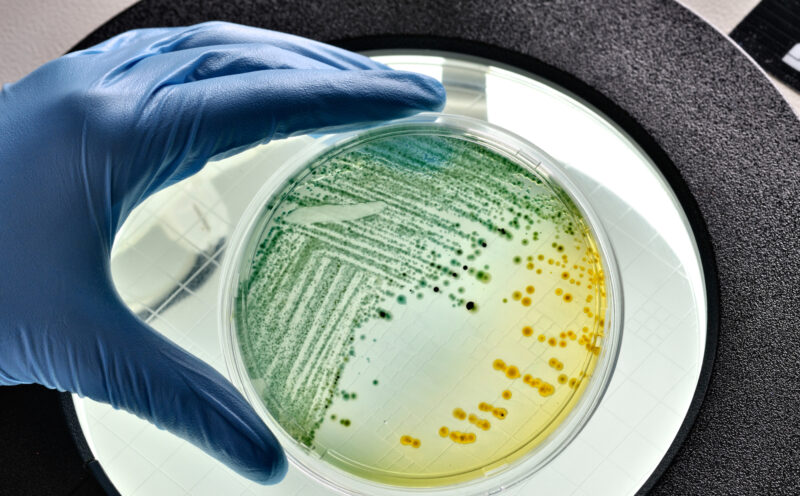
UCSC-led international collaboration sheds new light on bacterial mechanisms of antibiotic resistance

Health
-

Meet UC Santa Cruz entrepreneurs creating jobs and sparking innovation
As we enter entrepreneurship month this November, we’re celebrating the professors and alumni who are fueling job creation and creating opportunity
-

Effort aims to uncover the learning and reasoning potential of brain organoids
The Braingeneers team will test the ability of brain organoids to solve tasks in real time
-

New AI tool detects hidden cancer mutations
UC Santa Cruz researchers unveil DeepSomatic, a deep learning method that will help make genomic sequencing a routine part of how cancer is diagnosed and treated
-

NIH awards Fitnat Yıldız $7.7 million to find new molecular paths for preventing cholera
Grants will fund research to determine the mechanisms and consequences of a molecule produced by the bacteria that causes the disease
-
UCSC-led international collaboration sheds new light on bacterial mechanisms of antibiotic resistance
A collaboration between researchers in Santa Cruz and Puebla, Mexico, is working to eliminate the bacterial genes driving antibiotic resistance.
-

Carol Greider receives American Cancer Society Professor Award
The award includes a grant that will support Greider’s research that advances her Nobel-winning discovery of the DNA caps at the ends of chromosomes called telomeres
-

‘Future-guided’ AI improves seizure prediction
Engineers developed a deep learning method that manipulates time to make better predictions.
-

Grants to support brain organoid research on neuropsychiatric and developmental conditions
Two researchers received two-year grants from The Brain & Behavior Research Foundation.
-

New international collaboration poised to unlock more health-related discoveries
UC Santa Cruz removes geographic barriers and reduces costs with widened access to powerful Biomolecular cryoEM Facility
-

Smart device uses AI and bioelectronics to speed up wound healing process
A wearable device called “a-Heal,” designed by engineers at UC Santa Cruz, aims to optimize each stage of the wound healing process.

